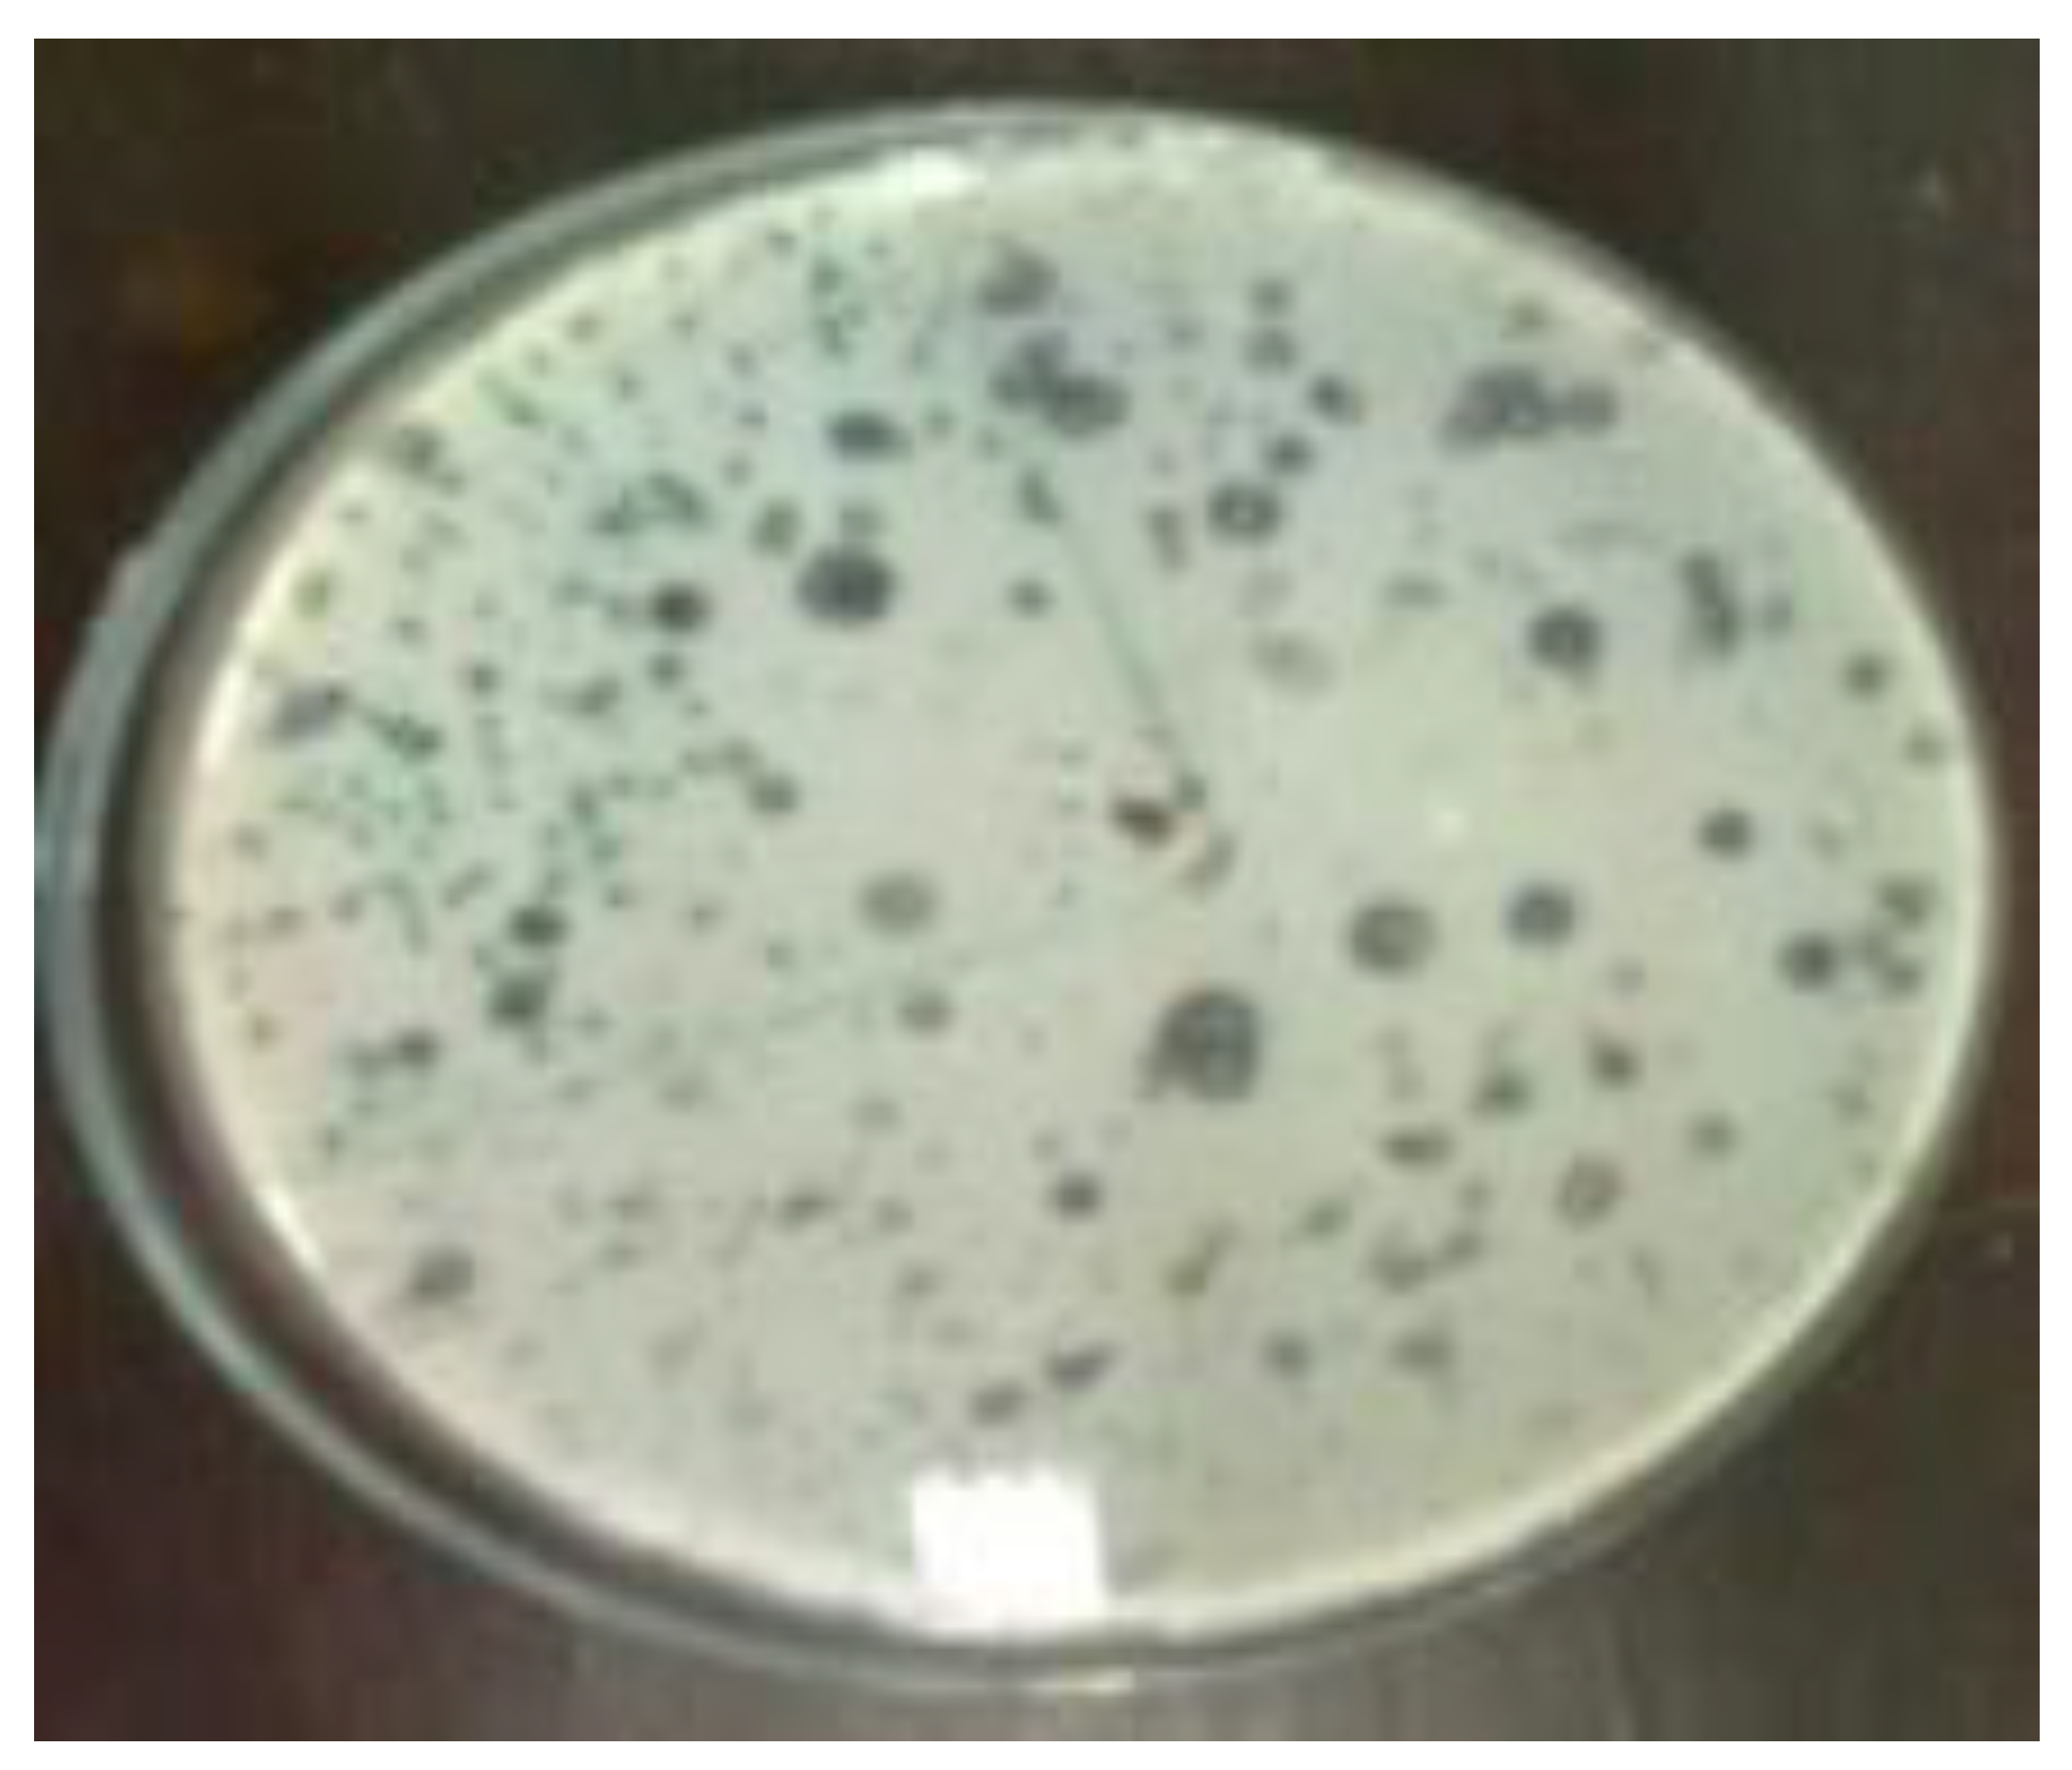
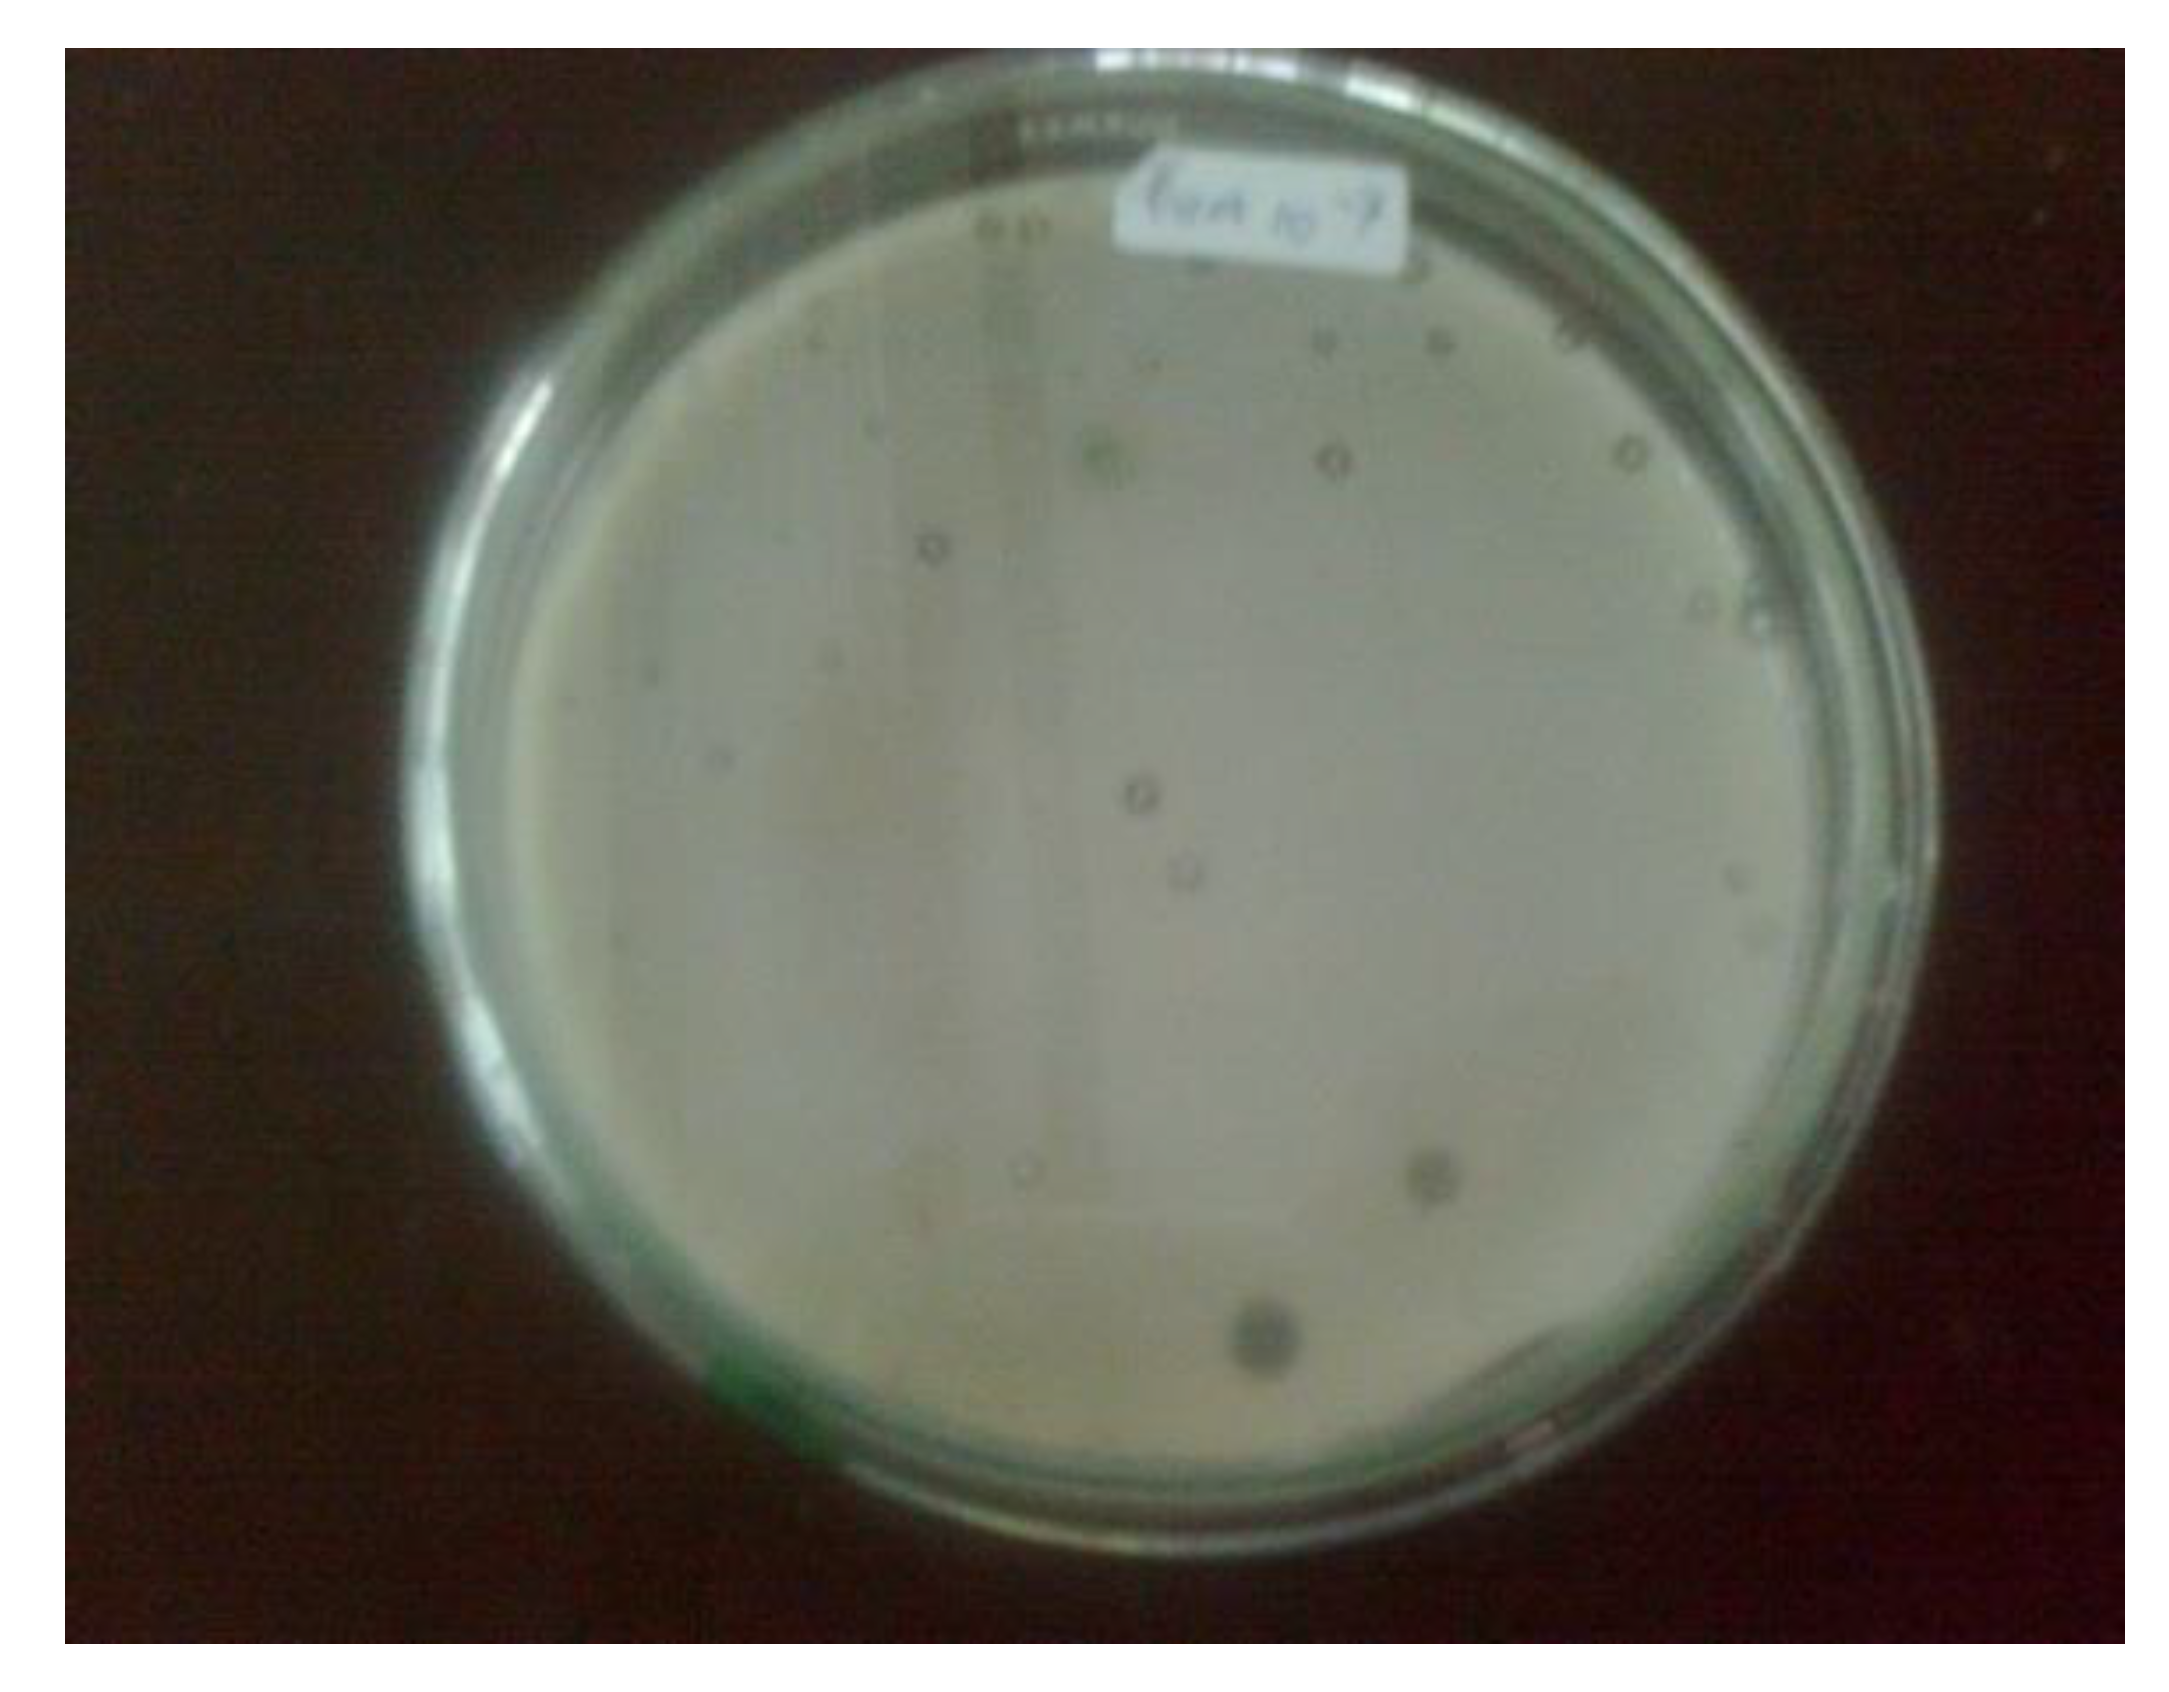
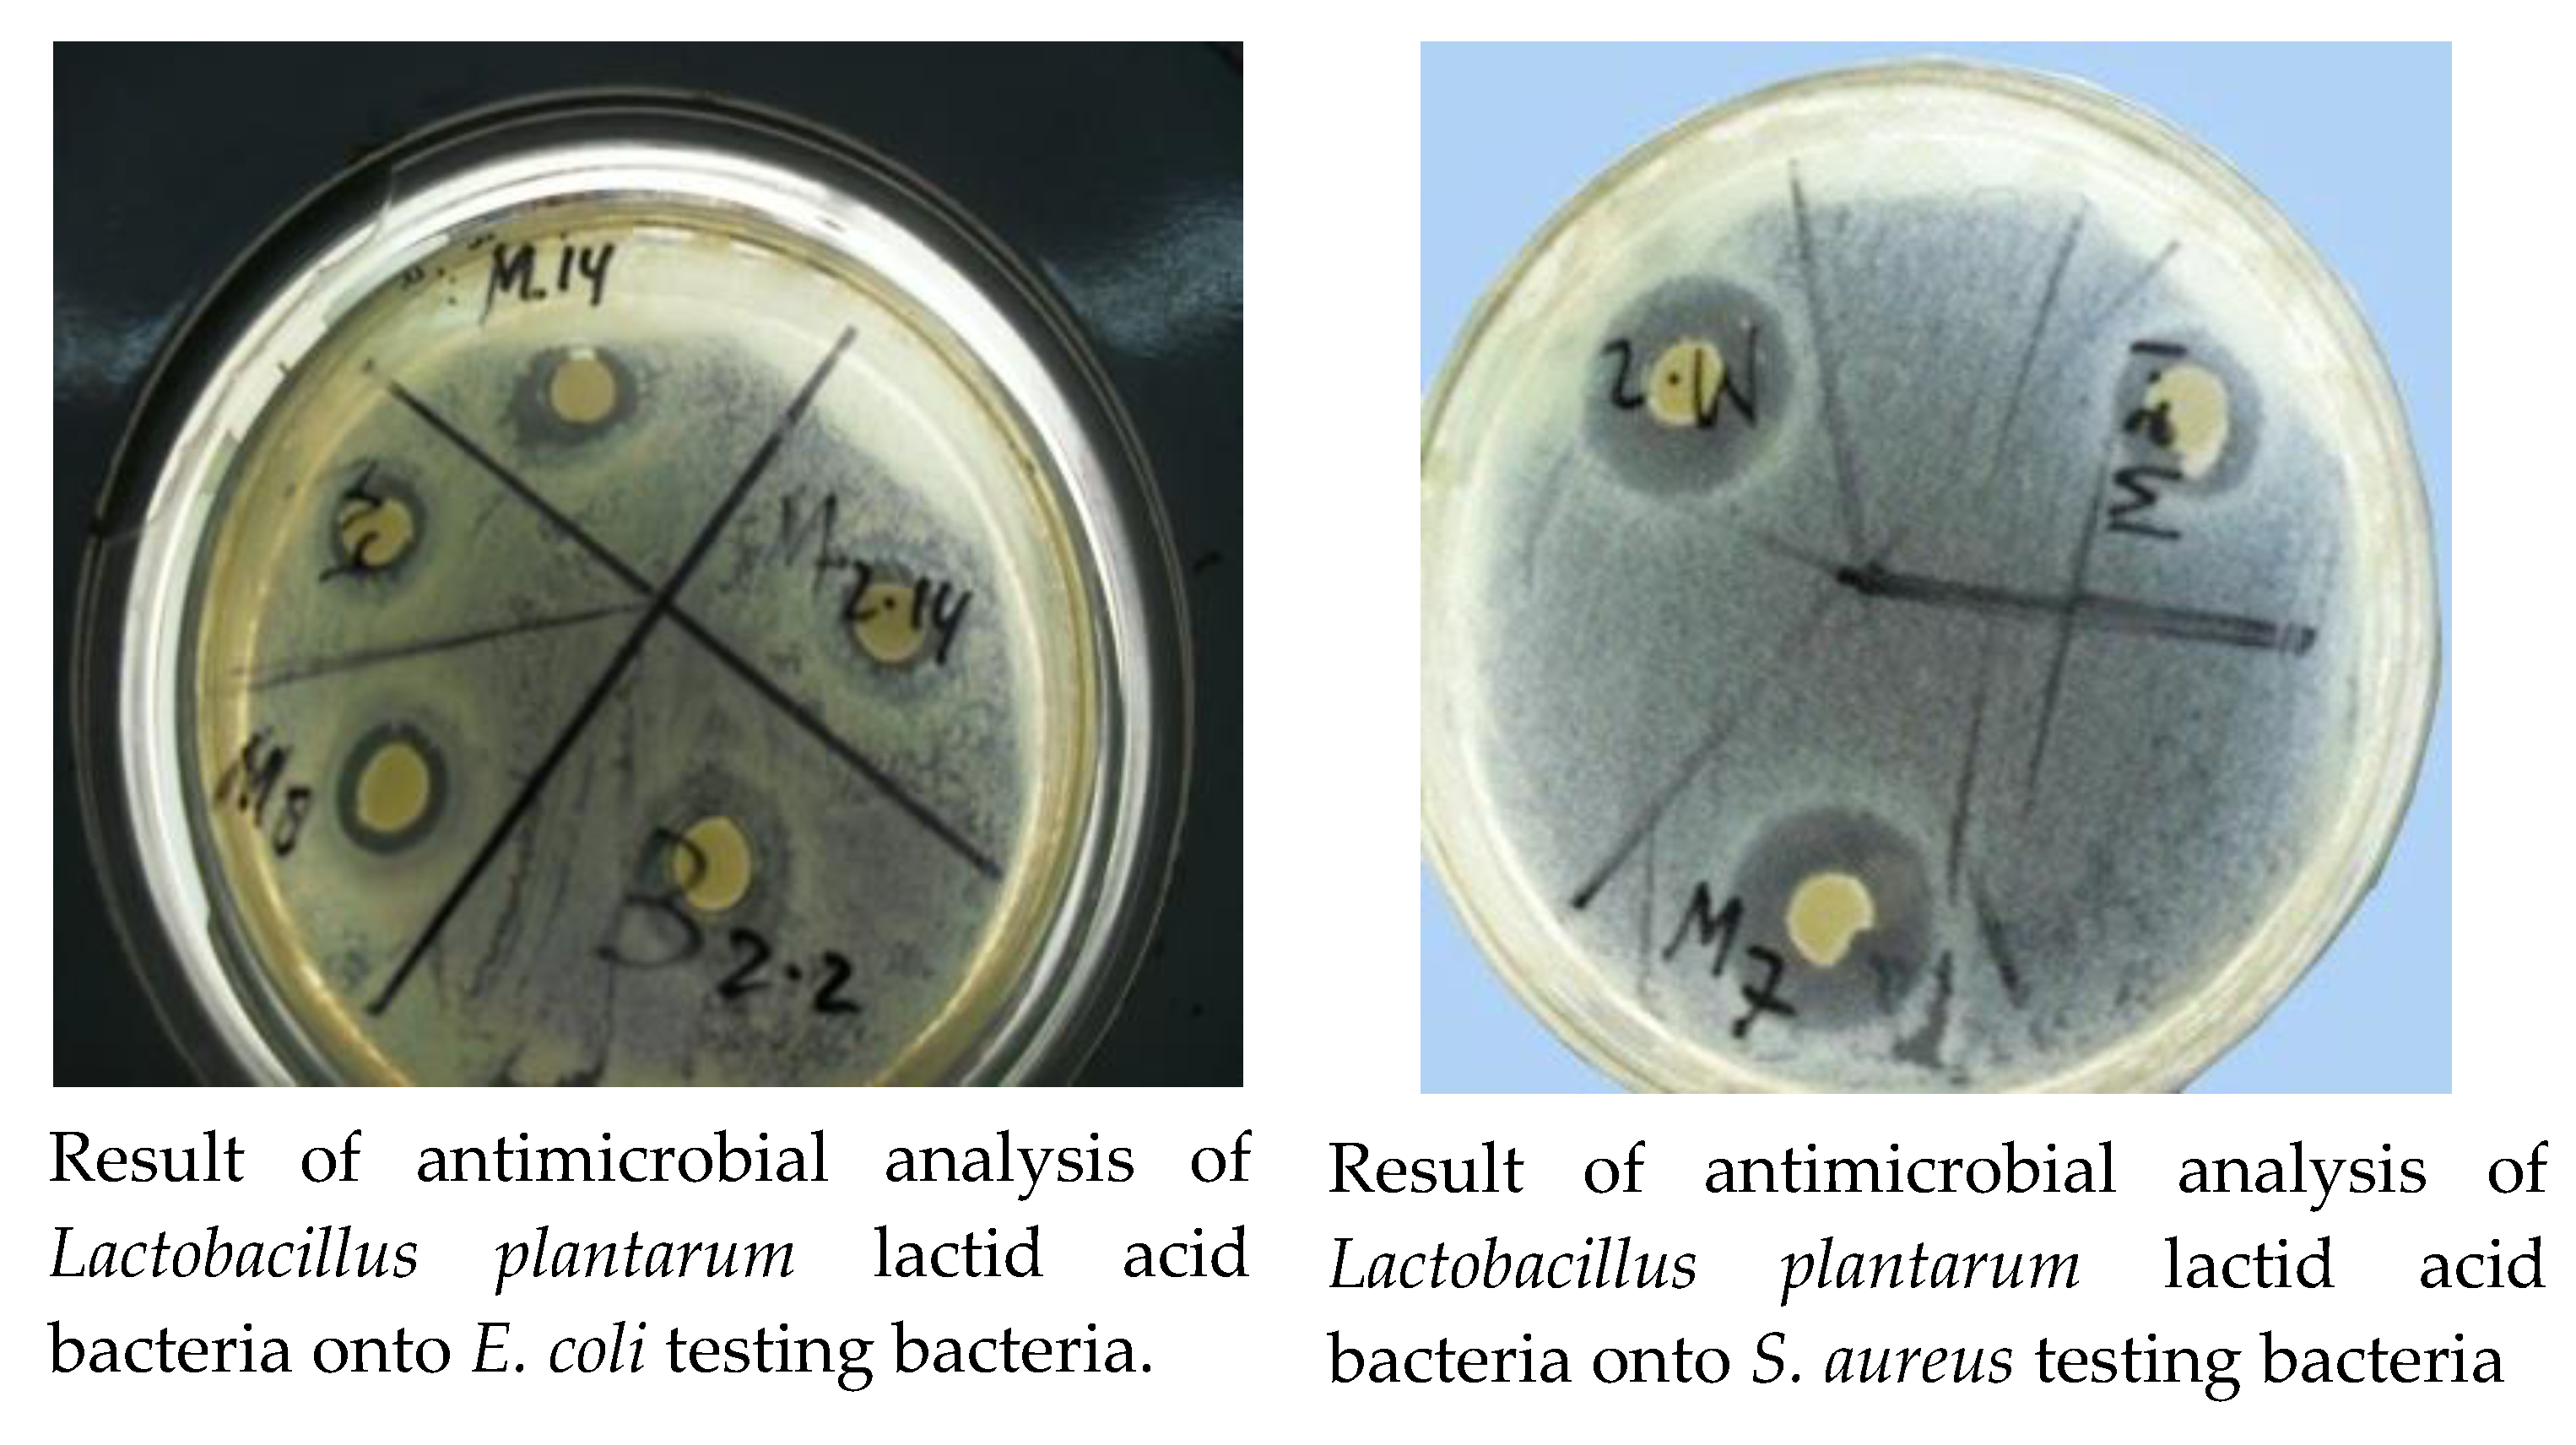

A Comparative Study of Virgin Coconut Oil, Coconut Oil and Palm Oil in Terms of Their Active Ingredients
Abstract
1. Introduction
2. Materials and Methods
2.1. Materials
2.1.1. Chemical Material
2.1.2. Instruments
2.2. The Standardization of the VCO
2.2.1. The Determination of pH
2.2.2. The Analysis of Fatty Acid Sample Using GC–MS
2.2.3. The Determination of Water Content
2.2.4. The Determination of Acid Number
2.2.5. The Determination of Iodine Number
2.2.6. The Isolation of Lactic Acid Bacteria
2.2.7. The Molecular Identification
2.2.8. Antimicrobial Analysis
3. Results and Discussion
3.1. Composistion and Properties of VCO, Coconut Oil and Palm Oil
3.2. Result of Lactid Acid Bacteria Isolation
3.3. Molecular Identification of Lactid Acid Bacteria
3.4. Result of Antimicrobial Analysis
4. Conclusions
Author Contributions
Funding
Acknowledgments
Conflicts of Interest
References
- Kumalaningsih, S.; Padaga, M. The Utilization of Microorganisms Isolated From Fermented Coconut Milk For The Production of Virgin Coconut Oil. J. Basic Appl. Sci. Res. 2012, 2, 2286–2290. [Google Scholar]
- Satheesh, N.; Prasad, N.B.L. Optimization of Parameters for Fermentative Production of Virgin Coconut Oil by Lactobacillus fermentum NDRI 141. J. Food Sci. Eng. 2012, 2, 44–50. [Google Scholar] [CrossRef]
- Marina, A.M.; Rosli, W.I.W.; Neoh, S.L. Frying quality of virgin coconut oil as affected by Zea mays extract. Sains Malaysiana 2014, 43, 1311–1315. [Google Scholar]
- Prasad, N.; Satheesh, N. Production of virgin coconut oil by induced fermentation with Lactobacillus plantarum NDRI strain 184. Hrvatski časopis za Prehrambenu Tehnologiju, Biotehnologiju i Nutricionizam 2014, 9, 37–42. [Google Scholar]
- Redjeki, S.; Kurniati, E. The Kinetic Reacion of Virgin Coconut Oil (VCO) Fermentation in an Ideal Bioreact, or Tank in a Batch Process. J. Chem. Chem. Eng. 2013, 7, 159–163. [Google Scholar]
- Wong, Y.C.; Hartina, H. Virgin coconut oil production by centrifugation method. Orient. J. Chem. 2014, 30, 237–245. [Google Scholar] [CrossRef]
- Khatir, Z.; Agustina, R.; Hartuti, R.; Fahmi, S. Improving Fermented Virgin Coconut Oil Quality by Using Microwave Heating. In Earth and Enviromental Science; IOP: Bristol, UK, 2020. [Google Scholar]
- Suryani, A.D.; Dharma, A.; Manjang, Y.; Arief, S.; Munaf, E.; Nasir, N. Antimicrobial and antifungal activity of Lactic Acid Bacteria isolated from coconut milk fermentation. Res. J. Pharm. Biol. Chem. Sci. 2014, 5, 1587–1595. [Google Scholar]
- Bawalan, D.D. Processing Manual for Virgin Coconut Oil, its Products and By-products for Pacific Island Countries and Territories; Secretariat of the Pacific Community: Noumea, New Caledonia, 2011. [Google Scholar]
- Carandang, E.V. Health Benefits of Virgin Coconut Oil. Indian Coconut J. 2008, 9, 8. [Google Scholar]
- Hayatullina, Z.; Muhammad, N.; Mohamed, N.; Soelaiman, I.N. Virgin coconut oil supplementation prevents bone loss in osteoporosis rat model. Evid.-Based Complement. Altern. Med. 2012, 2012. [Google Scholar] [CrossRef]
- Nurul-Iman, B.S.; Kamisah, Y.; Jaarin, K.; Qodriyah, H.M.S. Virgin coconut oil prevents blood pressure elevation and improves endothelial functions in rats fed with repeatedly heated palm oil. Evid.-Based Complement. Altern. Med. 2013, 2013. [Google Scholar] [CrossRef]
- Dumancas, G.G. Health Benefits of Virgin Coconut Oil. In Vegetable Oil: Properties, Uses and Benefits; NOVA: Burleigh, Australia, 2016; pp. 161–194. [Google Scholar]
- An, H.M.; Park, S.Y.; Lee, D.K.; Kim, J.R.; Cha, M.K.; Lee, S.W.; Ha, N.J. Antiobesity and lipid-lowering effects of Bifidobacterium sin high fat diet-induced obese rats. Lipids Health Dis. 2011, 10, 116. [Google Scholar] [CrossRef] [PubMed]
- Allen, S.; Jordan, S.; Storey, M.; Thornton, C.A.; Gravenor, M.; Garaiova, I.; Plummer, S.F.; Wang, D.; Morgan, G. Dietary Supplementation with Lactobacilli and Bifidobacteria Is Well Tolerated and Not Associated with Adverse Events during Late Pregnancy and Early Infancy. J. Nutr. 2010, 140, 483–488. [Google Scholar] [CrossRef] [PubMed]
- Abujazia, M.A.; Muhammad, N.; Shuid, A.N.; Soelaiman, I.N. The effects of virgin coconut oil on bone oxidative status in ovariectomised rat. Evid.-Based Complement. Altern. Med. 2012, 2012. [Google Scholar] [CrossRef][Green Version]
- Arlee, R.; Suanphairoch, S.; Pakdeechanuan, P. Differences in chemical components and antioxidant-related substances in virgin coconut oil from coconut hybrids and their parents. Int. Food Res. J. 2013, 20, 2103–2109. [Google Scholar]
- Pandiselvam, R.; Ramarathinam, M.; Plantation, C.; Beegum, S. Virgin Coconut Oil infused healthy cosmetics. Indian Coconut J. 2019, 13, 30–32. [Google Scholar]
- Kappally, S.; Shirwaikar, A.; Shirwaikar, A. Hygeia: Journal for drugs and medicines coconut oil—A review of potential applications. Hygeia J. Drugs Med. 2015, 7, 34–41. [Google Scholar]
- Varma, S.R.; Sivaprakasam, T.O.; Arumugam, I.; Dilip, N.; Raghuraman, M.; Pavan, K.; Rafiq, M.; Paramesh, R. In vitro anti-inflammatory and skin protective properties of Virgin coconut oil. J. Tradit. Complement. Med. 2019, 9, 5–14. [Google Scholar] [CrossRef]
- Law, K.S.; Azman, N.; Omar, E.A.; Musa, M.Y.; Yusoff, N.M.; Sulaiman, S.A.; Hussain, N.H.N. The effects of virgin coconut oil (VCO) as supplementation on quality of life (QOL) among breast cancer patients. Lipids Health Dis. 2014, 13, 139. [Google Scholar] [CrossRef]
- Krishna, A.G.G.; Raj, G.; Singh, B.A.; Kumar, P.K.P.; Chandrashekar, P. Coconut oil: Chemistry, production and its applications—A review. Indian Coconut J. 2010, 53, 15–27. [Google Scholar]
- Syukur, S.; Rajagukguk, H.; Syaputri, Y.; Iwahashi, H. Probiotic research in several products of virgin coconut oil from Padang, Indonesia. J. Phys. Conf. Ser. 2018, 1116. [Google Scholar] [CrossRef]
- Gesteiro, E.; Guijarro, L.; Sánchez-Muniz, F.J.; Vidal-Carou, M.D.C.; Troncoso, A.M.; Venanci, L.; Vinatea, V.J.; Quilez, J.; Anadón, A.; González-Gross, M. Palm Oil on the Edge. Nutrients 2019, 11, 2008. [Google Scholar] [CrossRef] [PubMed]
- Ong, H.C.; Masjuki, H.H.; Mahlia, T.M.I.; Silitonga, A.S.; Chong, W.T.; Yusaf, T. Engine performance and emissions using Jatropha curcas, Ceiba pentandra and Calophyllum inophyllum biodiesel in a CI diesel engine. Energy 2014, 69, 427–445. [Google Scholar] [CrossRef]
- Ong, H.C.; Milano, J.; Silitonga, A.S.; Hassan, M.H.; Shamsuddin, A.H.; Wang, C.T.; Mahlia, T.M.I.; Siswantoro, J.; Kusumo, F.; Sutrisno, J. Biodiesel production from Calophyllum inophyllum-Ceiba pentandra oil mixture: Optimization and characterization. J. Clean. Prod. 2019, 219, 183–198. [Google Scholar] [CrossRef]
- Silitonga, A.; Shamsuddin, A.; Mahlia, T.M.I.; Milano, J.; Kusumo, F.; Siswantoro, J.; Dharma, S.; Sebayang, A.; Masjuki, H.; Ong, H.C. Biodiesel synthesis from Ceiba pentandra oil by microwave irradiation-assisted transesterification: ELM modeling and optimization. Renew. Energy 2020, 146, 1278–1291. [Google Scholar] [CrossRef]
- Silitonga, A.S.; Masjuki, H.H.; Mahlia, T.M.I.; Ong, H.C.; Chong, W.T.; Boosroh, M.H. Overview properties of biodiesel diesel blends from edible and non-edible feedstock. Renew. Sustain. Energy Rev. 2013, 22, 346–360. [Google Scholar] [CrossRef]
- Mahlia, T.M.I.; Syazmi, Z.; Mofijur, M.; Abas, A.E.P.; Bilad, M.R.; Ong, H.C.; Silitonga, A.S. Patent landscape review on biodiesel production: Technology updates. Renew. Sustain. Energy Rev. 2020, 118. [Google Scholar] [CrossRef]
- Ghani, N.A.A.; Channip, A.A.; Hwa, P.C.H.; Ja’afar, F.; Yasin, H.M.; Usman, A. Physicochemical properties, antioxidant capacities, and metal contents of virgin coconut oil produced by wet and dry processes. Food Sci. Nutr. 2018, 6, 1298–1306. [Google Scholar] [CrossRef]
- Mansor, T.S.T.; Man, Y.B.C.; Shuhaimi, M.; Afiq, M.J.A.; Nurul, F.K.M.K. Physicochemical properties of virgin coconut oil extracted from different processing methods. Int. Food Res. J. 2012, 19, 837–845. [Google Scholar]
- Gupta, S.; Pandey, S. Isolation and characterization of bacteriocin producing bacteria from sweet lime juice. J. Pure Appl. Microbiol. 2018, 12, 953–960. [Google Scholar] [CrossRef]
- Khan, H. Production Characterization and Utilization of the Bacteriocin Produced by Enterococcus faecalis B9510. Appl. Chem. Biotechnol. 2013, 162, 1–186. [Google Scholar]
- Zhou, F.; Zhao, H.; Bai, F.; Dziugan, P.; Liu, Y.; Zhang, B. Purification and characterisation of the bacteriocin produced by Lactobacillus plantarum, isolated from Chinese pickle. Czech J. Food Sci. 2014, 32, 430–436. [Google Scholar] [CrossRef]
- Suryani, A.D. Isolation and Characterization of Bacteriocins Bacteria Lactobacillus Plantarum Strain NM178-5 from Fermentation Process with Contained on Coconut Milk. Transylv. Rev. 2016, 24, 614–628. [Google Scholar]
- Suryani, S.; Dharma, A.; Nasir, N. Isolation and identification of pathogenic bacteria secretion of chronic suppurative otitis media patients. Rasayan J. Chem. 2018, 11, 1139–1143. [Google Scholar] [CrossRef]
- Tolinački, M.; Kojić, M.; Lozo, J.; Terzić-Vidojević, A.; Topisirović, L.; Fira, D. Characterization of the bacteriocin-producing strain Lactobacillus paracasei subsp. Paracasei BGUB9. Arch. Biol. Sci. 2010, 62, 889–899. [Google Scholar] [CrossRef]
- Wang, Y.; Qin, Y.; Xie, Q.; Zhang, Y.; Hu, J.; Li, P. Purification and Characterization of Plantaricin LPL-1, a Novel Class IIa Bacteriocin Produced by Lactobacillus plantarum LPL-1 Isolated From Fermented Fish. Front. Microbiol. 2018, 9, 1–12. [Google Scholar] [CrossRef] [PubMed]
- Akinola, F.F.; Oguntibeju, O.O.; Adisa, A.W.; Owojuyigbe, O.S. Physico-chemical properties of palm oil from different palm oil local factories in Nigeria. J. Food Agric. Environ. 2010, 8, 264–269. [Google Scholar]
- Braga, J.D.; Lauzon, R.D.; Galvez, L.A. Physicochemical characterization of used coconut oil from vacuum frying of jackfruit (Artocarpus heterophyllus lam) pulp eviarc sweet variety as affected by frying cycle. Philipp. J. Sci. 2019, 148, 587–595. [Google Scholar]
- Marina, A.M.; Man, Y.B.C.; Amin, I. Virgin coconut oil: Emerging functional food oil. Trends Food Sci. Technol. 2009, 20, 481–487. [Google Scholar] [CrossRef]
- Kumar, V.; Kumari, A.; Angmo, K.; Bhalla, T.C. Isolation and characterization of lactic acid bacteria from traditional pickles of Himachal Pradesh, India. J. Food Sci. Technol. 2017, 54, 1945–1952. [Google Scholar]

| Type of the Oil | Fatty Acids | % | Acid Number | Saponification Number | %FFA | Iodine Number | pH | Water Content % |
|---|---|---|---|---|---|---|---|---|
| VCO (A) | Lauric Acid (C12:0) | 54.06 | 1.01 | 348.00 | 0.26 | 5.32 | 6.50 | 0.11 |
| Palmitic Acid | - | |||||||
| Stearic Acid(C18:0) | 12.03 | |||||||
| VCO (B) | Lauric Acid (C12:0) | 53.90 | 1.03 | 345.70 | 0.25 | 5.24 | 6.40 | 0.12 |
| Palmitic Acid (C16:0) | - | |||||||
| Stearic Acid (C18:0) | 12.01 | |||||||
| VCO (C) | Lauric Acid (C12:0) | 53.70 | 1.02 | 346.64 | 0.26 | 5.25 | 6.50 | 0.11 |
| Palmitic Acid (C16:0) | - | |||||||
| Stearic Acid (C18:0) | 11.9 | |||||||
| Coconut oil | Lauric Acid (C12:0) | 2.81 | 0.39 | 269.62 | 0.28 | 7.02 | 6.90 | 0.11 |
| Palmitic Acid (C16:0) | 2.31 | |||||||
| Stearic Acid (C18:0) | 2.65 | |||||||
| Palm Oil 1 | Lauric Acid (C12:0) | 0.45 | 0.39 | 204.00 | 0.51 | 51.00 | 6.60 | 0.09 |
| Palmitic Acid (C16:0) | 2.88 | |||||||
| Stearic Acid (C18:0) | - | |||||||
| Palm Oil 2 | Lauric Acid (C12:0) | - | 0.39 | 203.02 | 0.73 | 49.71 | 6.50 | 0.09 |
| Palmitic Acid (C16:0) | 24.42 | |||||||
| Stearic Acid (C18:0) | - |
| No. | Testing Bacteria | Lactobacillus plantarum | Lactobacillus paracasei |
|---|---|---|---|
| 1. | Escherichia coli | 16 | 16 |
| 2. | Listeria monocytogenes | 17 | 18 |
| 3. | Bacillus substiliss | 15 | 11 |
| 4. | Salmonella typhy | 12 | 11 |
| 5. | Staphylococcus aureus | 11 | 11 |
| 6. | Pseudomonas aeruginosa | 17 | 14 |
| 7. | Klebsiella | 13 | 12 |
| 8. | Staphylococcus epidermidis | 13 | 12 |
| 9. | Proteus | 14 | 13 |
© 2020 by the authors. Licensee MDPI, Basel, Switzerland. This article is an open access article distributed under the terms and conditions of the Creative Commons Attribution (CC BY) license (http://creativecommons.org/licenses/by/4.0/).
Share and Cite
Suryani, S.; Sariani, S.; Earnestly, F.; Marganof, M.; Rahmawati, R.; Sevindrajuta, S.; Mahlia, T.M.I.; Fudholi, A. A Comparative Study of Virgin Coconut Oil, Coconut Oil and Palm Oil in Terms of Their Active Ingredients. Processes 2020, 8, 402. https://doi.org/10.3390/pr8040402
Suryani S, Sariani S, Earnestly F, Marganof M, Rahmawati R, Sevindrajuta S, Mahlia TMI, Fudholi A. A Comparative Study of Virgin Coconut Oil, Coconut Oil and Palm Oil in Terms of Their Active Ingredients. Processes. 2020; 8(4):402. https://doi.org/10.3390/pr8040402
Chicago/Turabian StyleSuryani, Suryani, Sariani Sariani, Femi Earnestly, Marganof Marganof, Rahmawati Rahmawati, Sevindrajuta Sevindrajuta, Teuku Meurah Indra Mahlia, and Ahmad Fudholi. 2020. "A Comparative Study of Virgin Coconut Oil, Coconut Oil and Palm Oil in Terms of Their Active Ingredients" Processes 8, no. 4: 402. https://doi.org/10.3390/pr8040402
APA StyleSuryani, S., Sariani, S., Earnestly, F., Marganof, M., Rahmawati, R., Sevindrajuta, S., Mahlia, T. M. I., & Fudholi, A. (2020). A Comparative Study of Virgin Coconut Oil, Coconut Oil and Palm Oil in Terms of Their Active Ingredients. Processes, 8(4), 402. https://doi.org/10.3390/pr8040402

